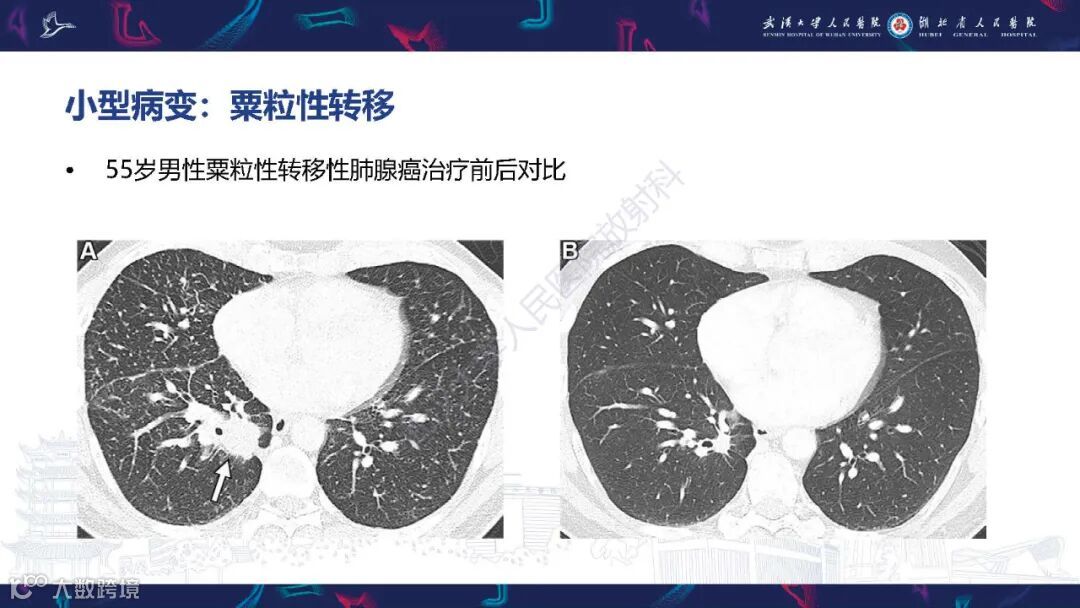

·END·
精彩推荐:
力荐!医学影像专业必关注的8个公众号
全网最全的解剖图库,千万不要错过 300+神经、头颈系统超全影像文章汇总
全网最全头颅影像解剖学,不容错过(更新版) 全网最全大关节影像解剖,不容错过(更新版) 影像科急诊必备手册,必点收藏 脊柱、脊髓解剖及常见疾病汇总(41篇) 乳腺解剖及影像学检查详细汇总 心胸系统文章汇总(132篇) 全网最全全身X线高清图谱

更多精彩医学影像内容,尽在鼎湖影像 权威医学影像公众号,欢迎您的关注↓↓
 ↓↓ 欢迎进入鼎湖学堂
↓↓ 欢迎进入鼎湖学堂
 鼎湖影像
鼎湖影像

·END·
精彩推荐:
力荐!医学影像专业必关注的8个公众号
全网最全的解剖图库,千万不要错过 300+神经、头颈系统超全影像文章汇总
全网最全头颅影像解剖学,不容错过(更新版) 全网最全大关节影像解剖,不容错过(更新版) 影像科急诊必备手册,必点收藏 脊柱、脊髓解剖及常见疾病汇总(41篇) 乳腺解剖及影像学检查详细汇总 心胸系统文章汇总(132篇) 全网最全全身X线高清图谱

更多精彩医学影像内容,尽在鼎湖影像 权威医学影像公众号,欢迎您的关注↓↓
 ↓↓ 欢迎进入鼎湖学堂
↓↓ 欢迎进入鼎湖学堂

